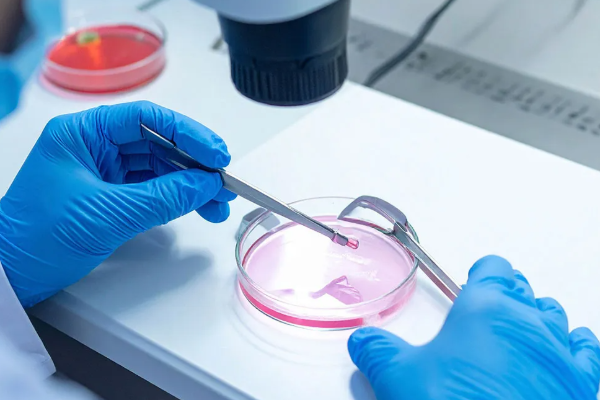
197 குழந்தைகளை அபாயத்தில் தள்ளிய விந்தணு தானமளிப்பவர் | Sperm Donor Who Put 197 Children At Risk Cancer 197 குழந்தைகளை அபாயத்தில் தள்ளிய விந்தணு தானமளிப்பவர் | Sperm Donor Who Put 197 Children At Risk Cancer

197 குழந்தைகளை அபாயத்தில் தள்ளிய விந்தணு தானமளிப்பவர்
புற்றுநோய் அபாயத்தை அதிகப்படுத்தும் அரிதான மரபணுப் பிறழ்வைக் கொண்டிருந்த ஒரு விந்தணு தானமளிப்பவர், ஐரோப்பா முழுவதும் குறைந்தது 197 குழந்தைகளுக்குத் தந்தையாகியுள்ளதாக அதிர்ச்சித்தகவல் வெளியாகியுள்ளது.
இந்தப் பிறழ்வு கொண்ட விந்தணுவைப் பயன்படுத்திய குடும்பங்களுக்குச் சர்வதேச அளவில் அதிர்ச்சி ஏற்பட்டுள்ளதுடன், விந்தணு தானத்தில் உள்ள வரம்புகள் மற்றும் பரிசோதனை நடைமுறைகள் குறித்துக் கேள்விகள் எழுந்துள்ளதாக சுட்டிக்காட்டப்பட்டுள்ளது.
விந்தணு தான நடைமுறைகள்
இந்த அநாமதேய தானமளிப்பவர், தான் பிறப்பதற்கு முன்பே மரபணுவில் புற்றுநோயைத் தடுப்பதில் முக்கியப் பங்கு வகிக்கும் பிறழ்வைக் கொண்டிருந்ததாக கூறப்படுகின்றது. தானமளிப்பவர் ஆரோக்கியமாக இருந்தாலும், அவரது விந்தணுக்களில் 20% வரை இந்த ஆபத்தான மாறுபாட்டைக் கொண்டிருந்தன.
பாதிக்கப்பட்ட விந்தணுவைப் பயன்படுத்திப் பிறந்த குழந்தைகள், லி ஃபிரௌமெனி சின்ட்ரோம் எனும் தீவிர நிலையுடன் பிறக்கும் அபாயம் உள்ளது. இது அவர்களுக்கு வாழ்நாளில் 90% வரை புற்றுநோயை உருவாக்கும் அபாயத்தை ஏற்படுத்துகிறதாகவும் , குறிப்பாகக் குழந்தைப் பருவத்திலேயே புற்றுநோய் ஏற்படும் வாய்ப்பு அதிகம்.
பாதிக்கப்பட்ட 67 குழந்தைகளில் 23 பேருக்கு இந்த மாறுபாடு உள்ளது கண்டறியப்பட்டதாகவும், அவர்களில் 10 பேருக்கு ஏற்கனவே புற்றுநோய் இருப்பது கண்டறியப்பட்டதாகவும் மருத்துவர்கள் அறிக்கை அளித்துள்ளனர்.
அதேவேளை சில குழந்தைகள் இளம் வயதிலேயே இறந்துவிட்டதாகவும் கூறப்படுகிறது. டென்மார்க்கின் ஐரோப்பிய விந்தணு வங்கி இந்த விந்தணுவை 17 ஆண்டுகளாக விநியோகித்துள்ளது.
இந்த விந்தணு 14 நாடுகளில் உள்ள 67 கருவுறுதல் மருத்துவமனைகளால் பயன்படுத்தப்பட்டுள்ளதாக தெரிவிக்கப்படுகிறது.
ஐரோப்பிய விந்தணு வங்கி பாதிக்கப்பட்ட குடும்பங்களுக்குத் தங்கள் வருத்தத்தைத் தெரிவித்ததாகவும், பிரச்சினை கண்டறியப்பட்டவுடன் தானமளிப்பவரின் விந்தணுவைப் பயன்படுத்துவதை உடனடியாகத் தடுத்துவிட்டதாகவும் தெரிவித்துள்ளது.
இந்நிலையில் பாதிக்கப்பட்ட பெற்றோர் தாங்கள் சிகிச்சை பெற்ற மருத்துவமனையைத் தொடர்பு கொள்ளுமாறு அறிவுறுத்தப்பட்டுள்ளனர்.